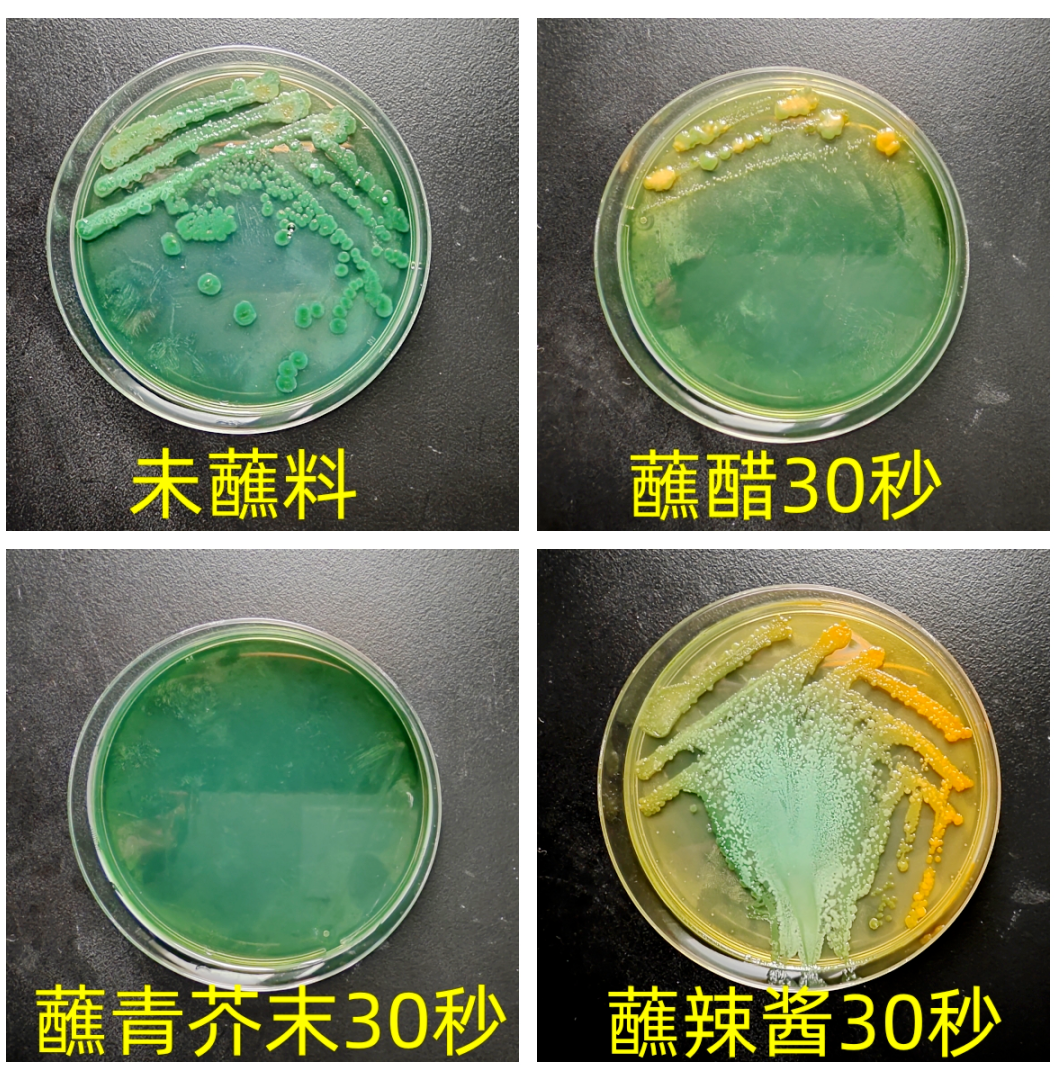
图片

食安科普指南
第六期
生吃牡蛎须谨慎

俗语说“冬至到清明,蛎肉肥津津”,当下是牡蛎大量上市且最为鲜美的季节。作为一种高蛋白、低脂肪、容易消化的食物,牡蛎被称为“海底牛奶”。同时,牡蛎含有十多种人体所需氨基酸,其谷氨酸、天冬氨酸、甘氨酸和丙氨酸等呈味氨基酸的含量较高,被誉为“天下第一鲜”。牡蛎做法很多,但部分消费者却喜欢生食牡蛎,每年牡蛎上市季节,更有不少消费者因生食牡蛎出现呕吐、腹泻等症状。那么,这些症状与牡蛎有直接关系吗?本期“食安科普”继续用实验为您揭开谜底。
实验基本情况
时间:2024年1月
地点:宁海县食品检测中心
检测项目:副溶血性弧菌
检测标准:GB 4789.7-2013 食品安全国家标准 食品微生物学检验 副溶血性弧菌检验
实验一
检测市售牡蛎的副溶血性弧菌阳性率
工作人员从宁海牡蛎采收点和各大城乡菜场随机购买牡蛎共16份。用GB 4789.7-2013检测牡蛎中副溶血性弧菌的阳性情况。

检测结果如下:

从以上结果能看出,8份来自牡蛎采收点的样品检出副溶血性弧菌样品1份,阳性率为12.5%,8份菜场购买的样品检出副溶血性弧菌样品3份,阳性率为37.5%,整体样品的阳性率为25%。
牡蛎检出阳性,这就说明生食牡蛎并不安全。不过有些消费者在生食牡蛎时会蘸一蘸醋、芥末、辣酱,这样就没有风险了吗?
实验二
蘸料对副溶血性弧菌的杀灭效果
工作人员从市场购买香醋、青芥辣、辣酱,在青芥辣、辣酱中加入少许凉开水,调成酱汁,将12#(有检出副溶血性弧菌)样品分别取30克左右放入三种准备好的蘸料汁中约30秒(牡蛎整只浸没),再检测。

结果显示,经蘸料浸泡的与未浸泡相比,杀菌效果最好的为青芥末,其次是醋,辣酱杀菌效果最差(见下图):
温馨提示
1.牡蛎中副溶血性弧菌检出率较高,也会携带诺如病毒和霍乱弧菌等病原体,所以尽量不吃生牡蛎。
2.选择肉质饱满、色泽鲜亮、气味清香的牡蛎,如出现肉质塌陷、有异味时应弃购。
3.牡蛎性寒,嘌呤含量较高,有肠胃炎或痛风患者应尽量少食。
4.牡蛎营养丰富,也容易滋生微生物,所以最好能低温密封保存并尽快食用。
(来源:宁海发布)